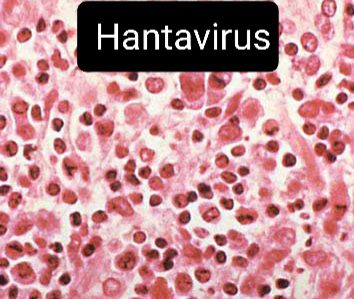

434* 08 luglio 2021
In più occasioni, parlando del ratto, abbiamo accennato ad alcune malattie trasmesse dal roditore.
Una di queste è l’Hantavirus di cui i sintomi si presentano nell’uomo sotto forma di due diverse malattie, una a carico dei reni, l’altra a carico dei polmoni.
Approfondiamo.
Le infezioni da hantavirus sono diffuse in particolar modo nelle zone rurali.
Il virus è trasmesso dai roditori mediante le feci e l’urina. La malattia non si trasmette invece da uomo a uomo, ma solo da animale a uomo.
Se più raramente il contagio nell’uomo avviene con il morso del ratto che trasferisce il virus direttamente con la saliva, più frequente il contagio avviene attraverso l’inalazione del virus rilasciato dagli escrementi dei roditori.
Oppure avviene toccando il terreno contaminato.
Il Ministero della Salute consiglia di evitare l’esposizione ai roditori e ai loro escrementi.
È buona prassi lavarsi spesso le mani, non sedersi a terra nelle zone che possono essere contaminate e indossare una mascherina qualora si faccia opere di pulizia sollevando polvere.
I sintomi dell’hantavirus iniziano come una sindrome tipo influenzale a febbre alta, mal di testa, brividi, dolore addominale, congiuntivite, rossore al viso, disturbi respiratori.
L’infezione può durare fino a un mese, ma se trascurata, può portare complicanze anche gravi, come nefropatia epidemica, emorragie e sindromi polmonari.
Farmaci antivirali sono in grado di ridurre la malattia.
È notizia di pochi giorni fa di un primo caso sospetto di “febbre del topo” in provincia di Treviso: un uomo di 50 anni, residente nella zona di Vittorio Veneto, è stato ricoverato all’ospedale di Costa con i sintomi tipici dell’hantavirus.
Settimane prima, il virus aveva colpito un cittadino sloveno domiciliato a Cervignano, cittadina del Friuli.
Come riportato da La Tribuna di Treviso, “il paziente è stato ricoverato con febbre alta e disturbi polmonari.
Oggi le sue condizioni sarebbero in miglioramento ma il personale sanitario sta ancora tenendo il 50enne sotto stretta osservazione, idratandolo e curandolo con antibiotici ad ampio spettro.
L’ipotesi del personale sanitario è che il paziente sia entrato in contato con il virus raccogliendo carcasse dei topi morti.
L’Ulss 2, nel frattempo, ha deciso di disporre le analisi di laboratorio per capire l’esatta natura del virus.
La moria di topi che ha colpito la Pedemontana nei giorni scorsi non ha ancora una spiegazione accertata scientificamente.
L’esito delle analisi è atteso per le prossime ore, nel frattempo l’Ulss 2 ha lanciato un appello ai cittadini: massima attenzione all’igiene e prudenza nel caso in cui si trovino topi morti nel giardino o nelle vicinanze della propria abitazione.
Non è escluso che, anche utilizzando guanti e sacchetti, l’hantavirus possa trasmettersi lo stesso”.
Vuoi saperne di più? Scrivici senza impegno!